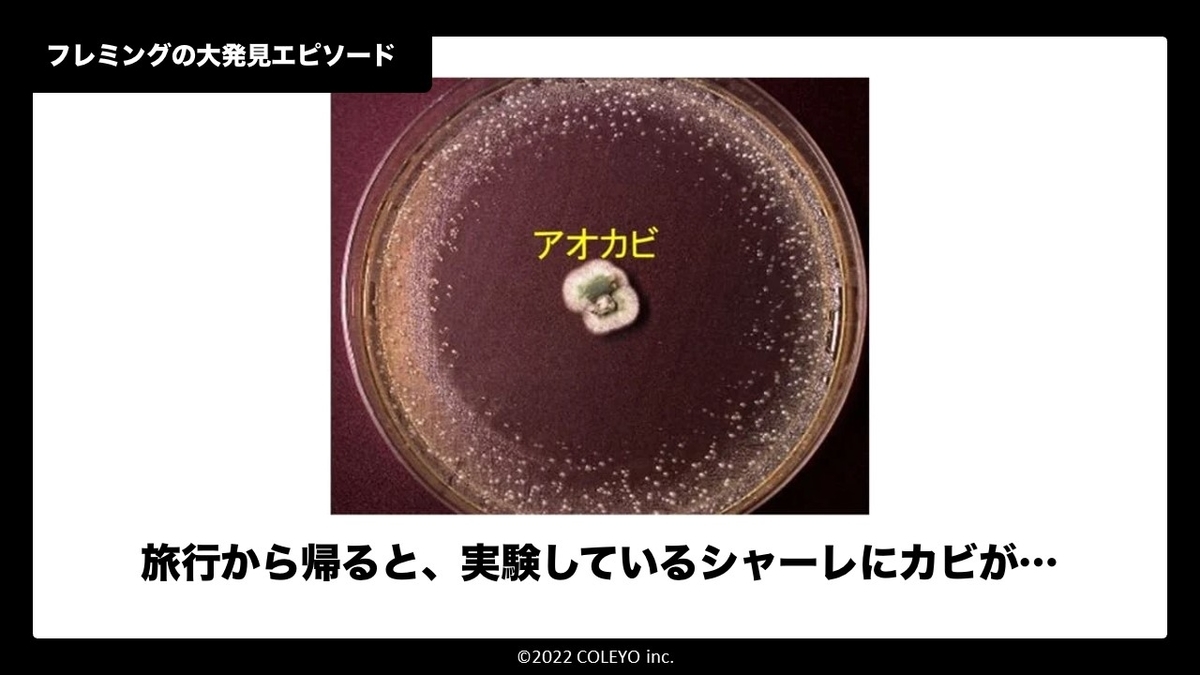

「自分のミツバチの幻のはちみつをつくりたい」

「まぼろしのハチミツ」について知っていますか?
ニホンミツバチのはちみつは、「まぼろしのハチミツ」と言われるほど、希少で、とても美味しいんです。
プロジェクト
僕のやろうと思っているプロジェクトは「身近な所で、養蜂をやりニホンミツバチを養ってハチミツを採取し、『自家製 はちみつ』として、人にふるまう。」という内容のプロジェクトです。
このプロジェクトの魅力
ニホンミツバチがいると、自然が増えます。そして、頑張って蜜を集めるハチから元気をもらえます。
======養蜂場所を大募集中です!!!🐝🐝======
======================================
自分の想い
どうして、ぼくが養蜂をやろうと思ったかというと、テレビで、ニホンミツバチの生態ついて知り、ニホンミツバチの賢さと可愛さにとても惹かれたからです。
ニホンミツバチは、自然を豊かにするし、果実などの受粉をして、自然と人間両方の役にたちます。
それに、ニホンミツバチは、もふもふで、とても可愛いと思います。しかし、最近ミツバチ自体が急激に減ってきています。
だから、養蜂をやって、ニホンミツバチを増やしたいと思っています。
これまでの取り組み
最初は、養蜂について、あまり知らなかったので、養蜂について調べたり、養蜂の研究をしている大学の教授に、自分で連絡をして教授に会いに行き、養蜂について教えて貰ったり、ミツバチの巣箱を作ったりました。

そして、僕が通っているstudioあおという教室のビルのオーナーに許可を得ようとしましたが、断られてしまい、養蜂をやる場所がなくなってしまいました。やる場所を探しつつ、区役所の屋上にある庭園でやっている、都市養蜂家の人にはなしを聞きに行って、養蜂のお手伝いをさせてもらっていました。

養蜂は難しいと思われるかもしれませんが、銀座や、京都のホテルの屋上、JR岡山駅の屋上などで養蜂をやっています。これらは、セイヨウミツバチという採蜜量が多い種類でやっています。
都市養蜂は西洋ミツバチの方が主流ですが、僕がやろうと思っている日本ミツバチという種類は 蜜の量は少ないけれども セイヨウミツバチと比べるとおとなしく、手間も少なく 蜜がすごく美味しいです。なので、幻の蜂蜜と呼ばれています。
そして、はちと聞くと危ないイメージがあるかもしれませんが、ニホンミツバチは、大人しいし、毒は、他のハチより毒は弱いです。巣箱の管理は、週一〜週二で巣箱を見に行く予定です。その他のスズメバチ対策などの作業もやります。僕の活動は習い事のstudioあおのスタッフに協力してもらいながら活動しています。なので、サポートしてくれる大人がいます。巣箱を見にいくなどの巣箱や、ハチの世話は、責任を持って行います。
ニホンミツバチは、他のはちとくらべると攻撃性は、すごく低いです。
もしハチが近づいて来たら、急な動きをしない、黒い服を着て巣箱に近寄らない、匂いの強い物を見につけて巣箱に近寄らない、などの対応をすれば、さされる心配もそこまでありません。
結論
僕は、ニホンミツバチがとても可愛いので大好きです。なので養蜂をやって、可愛いニホンミツバチを増やしたいです。
僕は、テレビでうまく役割分担をして生きているニホンミツバチに興味を持ちました。そして、実際に生きているミツバチをみたときに、もふもふで、目が大きくてすごく可愛いと思いました。ミツバチについて調べていると、ミツバチが減ってきているという現状も知りました。
こんなにかしこいし、かわいいミツバチが数十年後には、ほとんど見られなくなると考えるととても悲しいので、養蜂をやって少しでもミツバチを増やそうと思いました。

スケジュール
実施のスケジュールは、こんな内容で予定しています!
・12月 場所を決定する
・1月 すのこの作成 待ち箱ルアーの購入
・2月 巣箱の設置
こんな人に協力して欲しい!
ちょっとでも当てはまる人、ご連絡ください!
・養蜂をやっているけど、ちょっと場所を貸してあげられそう!
・山の方につかっていない土地がある!
・知人が養蜂をやっている
僕は、十二月までに場所を見つけなければいけないのでもし心当たりがあったら、早めに教えてほしいです。
==ご連絡はこちらからお待ちしています!!🐝🐝==
======================================
京都先端科学大学名誉教授の坂本文夫教授に応援のコメントをいただきました。
ーーーーーーーー
小・中学生の皆さんが何かに夢中になって没頭する姿は良いもので、子供の頃を思い出して応援したくなるものです。
勝又君はニホンミツバチのファンになり、もっと身近に接したいという気持ちを持ち続けています。
書籍やウェブサイトから学習して知識も豊富で、色々なトラブルの対処法も勉強しています。
あとは自分で群れを持って養蜂を実践するだけです。
ニホンミツバチの養蜂を実践する場を提供できる方が居られたら、是非ご協力下さい。宜しくお願い致します。
京都先端科学大学名誉教授
京都ニホンミツバチ研究所
農学博士 坂本 文夫

ーーーーーーーー
まとめ
ニホンミツバチがいると自然が増え、花の受粉がスムーズに出来るので敷地内の美化にも繋がります。そして、何より、ハチから元気をもらえます。
ハチが元気に飛んでいて、自然がたくさんある場所を想像すると、すごく夢があるし、そうすれば、たくさんの人とハチが一緒にいる新しい場所になるかも知れません。
もし出来そうな場所があれば、ちょっとした情報でもよいので教えて欲しいです。
よろしくお願いします!!
======養蜂場所を大募集中です!!!🐝🐝======
======================================
《13歳》魚ぎらいな子どもたちを減らしたい!楽しみながら魚が食べたくなるボードゲーム

みてくださっている人たちこんにちは。中学生の1年生の諸岡遼哉です。
僕は魚が大好きです。どれくらい好きかというと4歳の頃から魚釣りをはじめて、夏になったら月に3回くらい釣りに行くくらいです(関係ないけどさかなクンに憧れていますw)
そんな僕がなんと魚のボードゲームをつくってしまいました!
今回はそのボードゲームについて知ってもらい、買ってもらえたらうれしいと思ってこのブログを書きました。このボードゲームを通して魚の魅力、美味しさ、捕れる地域や生態を知ってくれればとてもうれしいです。
長くなると思うけど最後までぜひみてください。

このボードゲームをつくった理由
もともと、魚が好きで魚の魅力について知ってほしいな〜と思っていました。
あるとき学校で同級生に「魚かお肉どっちがすき?」というアンケートをとったことがあって、そのとき自分の大好きな魚が30人中5人しか魚が好きだと言う人がいなくて、ほとんどの人が「お肉が好き」なことがわかりました。
僕が好きな魚の魅力をもっと色んな人に知ってもらい、魚の好きな人を増やしたいと思って、ボードゲームをつくり始めました。
ボードゲームプロジェクトの目標
このボードゲーム通して、「子どもたちに楽しく魚を知ってもらい、肉と同じくらい魚を好きになってもらいたい!」と思っています。
そしてそんな子どもたちを増やすために、目標にした販売数は50個で、2023年1月中に50の家族に届けたいと思っています。
現在売れているのは10個で、残り40個を売り切って完売をめざしています。
ボードゲームの内容
魚のことをもっと知ってもらうために、日本のご当地フィッシュを知れるボードゲームを作りました。このボードゲームは魚を題材にした釣りをするボードゲームです。

このボードゲームはすごろくとドンジャラをかけ合わせたようなゲームです。マスを移動しながらカードを手に入れ、カードのセットを揃えていくゲームです。
具体的には、釣りマスで釣りをして魚カードをゲットしたり、調味料カードと組み合わせて料理カードを手に入れたりします。必要なカードを組み合わせると、日本の漁業の有名な地域をゲットして、コインやポイントを集めることができます。

このゲームでは日本の漁業の有名な地域が書かれているので、どこの市町村がどの魚が有名かなどの名産やご当地の料理などもわかります。また、写真も魅力的なので、「この魚美味しそうだな〜〜!」などよだれを垂らしながら遊ぶこともできます。

このボードゲームをプレイしてもらった人からはこんな感想をもらいました。
■プレイしてくれた人にもらった感想
- それぞれの地域の魚の料理が知れるし、見ると美味しそうで魚を食べたくなる
- イベントカードをどのタイミングを使ったらいいか考えるので、戦略性があってよかった
普通のすごろくなどと違い、進むマスも自分で決めれるので面白い

ゲームの詳しい内容を知りたい方はこちらのプレイの説明動画をみてください。
魚が好きになる4つのメリット
いろんな食べ物を食べてほしいけど、子どもがお肉ばっかり食べて、魚をあまり食べてくれない。と、困っているお父さんやお母さん。
「子どもたちに楽しく魚を知ってもらい、肉と同じくらい魚を好きになってもらいたい!」と思ってつくったこのボードゲームには魚や魚料理が好きになる4つのメリットがあります。
魚嫌いな子どもに困っているお父さんやお母さんたちを助けることができるかもしれません!
メリット1. おいしそうな魚の料理写真で魚が食べたくなる!
このボードゲームのカードには、日本各地のおいしそうな魚料理の写真が載っています。それを見て、実際にプレイしてくれた人もおいしそうやな〜と言ってくれたりもしました。ゲームをすることで、もともと魚のことが嫌いだった子どもたちも、興味を持って「食べたい!」ということにつながると思っています。
メリット2. 日本全国のどこでどんな魚が有名か&おいしいかわかる!
魚嫌いな人は、もしかしたら初めて食べた魚がたまたまおいしくなかったのかもしれません。このボードゲームでは日本全国の魚の有名な地域を取り上げています。有名で美味しい魚が捕れる地域を知って、そこの魚を食べてみることでおいしい魚と出会い、魚の印象が変わるきかっけになるかもしれないです。
メリット3. 16種類の魚介類のカードがあるから魚の種類を知れる!
魚に興味のない人は、「切り身で魚が泳いでいると思っている」と聞いたことがあります。それくらい魚に興味のない人は魚の生き物としての姿を見たことがないのかもしれません。このボードゲームでは、魚の体全体を見てもらうことで、食材としてだけではなく、生き物として見てもらうことで魚に興味を持ってもらえると思っています。
メリット4. 調味料の簡単な組み合わせを知ることで魚料理がつくりたくなる!
魚の料理カードがあるので、いろんな魚の料理の種類を知ることができます。またゲームの中では調味料を組み合わせたりするルールがあるので、このボードゲームをきっかけに、家族でつくってみようか!つくってみたいな!と思ってもらえると思っています。お家でつくってみたりすることで、家族で魚を楽しめることが増えるかもしれないと思っています。

3年かかったボードゲームづくり
そんな魚とボードゲームが好きな僕がつくったこのボードゲームですが、中学生の僕がボードゲームをつくったと聞くと、もしかしたらみなさんはそんなにクオリティが高くないんじゃないのかなと思うかもしれません。だけど、そんなことはありません。
このボードゲームは中学生の僕が遊び半分で作ったのではなく、真剣に作りました。

ボードゲームの企画については、自分で考えて作りながら、実際にボードゲーム関係の仕事をしているうえぼう先生にアドバイスをもらったりして作りました。
ボードゲームの制作も、自分たちでテスト印刷をしたあと、実際の商品は印刷業者の「萬印堂」に発注して制作しました。印刷費用の見積もりを出すと、なんと11万かかることが判明しました。お金は教室の投資制度のPitch(ピッチ)を使って、スタッフののっしーに何度もプレゼンしました。
1度目のプレゼンでは、お金は出せないと言われました。なぜならメリットや良さを熱く語れたものの現実性が低かったからです。なので2回目のプレゼンでは一個あたり何円で売るのか利益はどれだけ出るのかなどの具体的な案を説明しました。さらに今後どこでいつどのようにボードゲームを売るのかなどの販売計画を作りプレゼンしました。
そんな感じで失敗を何度も重ねてついに投資してもらうことが決まりました。その結果、店に並ぶ他のボードゲームに負けないくらいのクオリティで作れたと思います。
しっぱいエピソード3選!
このボードゲームをつくるのは簡単か難しかったかで言うと、めちゃめちゃむずかしかったです。その結果、なんと3年間もかかってしまいました。
その3年間でたくさんのしっぱいをしてきたので、そのしっぱいエピソードを紹介しようと思います。
エピソード①:あまりにも運ゲーだった
ボードゲームづくりでまず難しかったことは、あまりにも運ゲーだったことです。はじめにつくった第1弾の「Fish is Life」。戦略がなくあまりにも運ゲーでした。

そして、大きく変えてつくった2作目の「Fish with MONEY」。ルールが複雑になったにもかかわらず、またもや運ゲーでした。何度も他の人たちや一緒に作ってくれていたスタッフと仮で遊んでみてアドバイスをしてもらったり、うえぼうさんにアイデアをもらったりしました。
スタッフのまっさんと1日中テストプレイしながらゲームアイデアを考えたりプチ合宿することもありました。そして、改良に改良を重ね、運ゲーの沼から脱出することが出来ました。そんなことをしている間に気づけば3年も経っていましたw それでも自分の納得いくボードゲームができとても良かったと思います。
エピソード②:市町村から写真をもらおうとした何回も断られた
このボードゲームでは、日本の漁獲量の多い9つの地域がでてきます。その地域でたくさん採れる魚介類を2種類ずつカードにしています。
初めはボードゲームにつかう魚カードの写真をフリー素材を使おうと思っていました。だけど、フリー素材だと販売する時に著作権にひっかかってしまうので、色々考えていたところ、日本全国の市町村に協力してもらうことを思いつきました。市町村に写真を提供してもらい、それを売ることによってPRにもなると思ったからです。
それで、まずは魚の有名な市町村を調べました。そしてその市町村の漁業関連のメールアドレスを調べて、写真をくれないかとお願いのメールをすることにしました。すると、なんと何10回も断られました。それでも諦めずいろいろな市町村にお願いした結果ついに9個の市町村から16枚の魚と料理の写真を集めることができました。
こちらの市町村にご協力いただきました!ありがとうございました!
岩手県 大船渡市、宮城県 気仙沼市、静岡県 下田市、静岡県 南伊豆町、長崎県 長崎市、北海道 浜中町、北海道 稚内、青森県 八戸市、島根県 浜田市


そして、制作して報告すると市町村の方からこんなコメントももらうことができました。
コメント1
私個人としての意見ですが、わかりやすく目を引くデザインがとても素敵だと感じました。たくさんの魚の魅力が伝わるボードゲームになると思いますので、完成まであと一息、頑張ってください!諸岡さんの思い描いた形で完成されますよう、心より応援しております。
コメント2
ボードゲームのデザイン完成おめでとうございます。当課職員一同、そのクオリティの高さにとても驚いておりました。(中略)プレーヤーに“自主的な学び”を促す工夫が施されており諸岡様の目的である「魚の魅力を知ってもらう」上での第1歩に相応しいゲームに仕上がっていると感じました。
エピソード③:販売をスタートしたのに、売れない‼︎
これは今困っていることです!!(泣)
みんなが買いやすいようにネットで買える「BOOTH」を使って販売したり、どんな商品かわかるようにstudioあおのFacebookで動画を流してみたりしてみましたが、なかなか売れません。目標は50個で、現在売れているのは10個です。
そしてこの問題を解決するために僕はこのブログを作りました。
今まで一緒にテストプレイをしてアドバイスをもらったり、色々な人から助けをもらいました。プレゼンをしてお金を投資してもらいました。なので僕はどうしてもこれを今売れ残っている分を売りきって、いろんな人に魚の魅力を届けたいと思っています。
最後に
僕のダラダラした文章にここまで付き合ってくれてありがとうございます。このブログを読んで少しでも僕のボードゲームを知ってくれて、魚が好きになってくれればとても嬉しいです。
ちなみに、つくるきっかけになった「アンケートをとった学校の人たち」と一緒に遊ぶことも出来ました。(先生にボードゲームをする時間をくださいとむっちゃ頼みましたw)遊んでもらった人には「面白い」とか「この魚美味しそう」とか言ってもらうことができとても嬉しかったです。
もしこのブログをよんでくれた人が僕のボードゲームを知り、遊んで笑顔になってくれると僕はこのボードゲームを長い間かけて作ってよかったな〜と思います。
最初から最後までこのブログみてくださったみなさんのなかで、このボードゲームが面白そうだと思ったらぜひ買ってみてください。
▼▽▼▽▼▽購入はコチラから!▼▽▼▽▼▽
▼▽▼▽▼▽▼▽▼▽▼▽▼▽▼▽▼▽▼▽▼▽▼▽
最後まで読んでくれてありがとうございました。
商品1セット

■セット内容
・カード(91枚)
魚カード 40枚
料理カード 24枚
調味料カード 13枚
イベントカード 6枚
地域カード 8枚
・マップシート(1枚)
・プレイヤーシート(4枚)
・コマ(8個)
子どもにはいっぱい経験させてあげたいけど、なかなか時間を作れない...【保護者インタビュー第2弾】

タッチ保護者インタビュー第2弾の今回は、『時間がなくて、習い事の種類を増やせない...』
そんなお悩みを持って、タッチと出会った大園さんにお話を聞いてきました!
▽保護者インタビュー第1弾はコチラ!▽stud-io.hatenablog.com
- タッチに通っている凛ちゃんってどんな子?
- 子どもにはいっぱい経験させてあげたいけど、正直時間が全然ない...
- 【タッチの環境➀】好奇心が溢れ出る24種の体験!しかも、たった1つの習い事で!
- 【タッチの環境②】小学生が選挙で演説!?遊び感覚で学んじゃう授業!
- 誰かに頼る前に、まずは自分で考えてみる・やってみる!
- 親が子どもに見せてあげられる世界には限りがあるからこそ...
- 『タッチ』が気になる方へ、無料体験授業にご招待!

タッチに通っている凛ちゃんってどんな子?

子どもにはいっぱい経験させてあげたいけど、正直時間が全然ない...
タッチ北出:最初に、子育てで大変だなと感じる場面を教えてもらってもいいでしょうか?
そうですね~、やっぱり子どもと遊んだり、いろんな体験をさせてあげる時間がなかなか取れないところですね。うちは子どもが3人いて、共働きなので子どもそれぞれのサポートをきちんとできていないと感じることもあります。
北出:お子さんが3人いて、お仕事もあると、なかなか大変そうですね...
そうなんです。平日は学校の宿題や翌日の準備をすることに追われています。あと、子どもがやりたい習い事も、送り迎えの時間が取れないから、やらせてあげられないことも多いです。 ただ、子どもたちの興味が固まってしまう前にいろんな経験をさせてあげたいという想いは強くもっていまして。

【タッチの環境➀】好奇心が溢れ出る24種の体験!しかも、たった1つの習い事で!
北出:そんなお悩みを持った中での、タッチ入会の決め手って何だったんですか?
1つの習い事で、いろんな『体験』ができるところですね!子どもを外に連れ出す時間が少ない中で、たくさん体験できて興味の幅が広がると思いまして。
北出:タッチでの『体験』を通して、お子さんの変化って何かありましたか?
興味あることがどんどん広がるようになりました!今までだったら、娘が興味を持っていないことも、家で話すようになりました!
最近、家で魚が出てきた時に、魚の仕組みを楽しそうに教えてくれました!『漁業の授業』でトビウオを解剖した体験で興味を持ったようです!

他にも、『プログラミングの授業』でペッパーをプログラミングした時も、すごく楽しそうにプログラミングについて、話してくれました!
▽『漁業の授業』紹介記事はコチラ▽
【タッチの環境②】小学生が選挙で演説!?遊び感覚で学んじゃう授業!
子どもにとって、楽しみながら社会の仕組みを学ぶことができる授業になっているところも、印象に残っていますね!家では絶対話さない『お金の仕組み』や『政治の役割』みたいなものも、タッチ帰りには楽しそうに教えてくれるんです!
ただ勉強してるんじゃなくて、ゲーム感覚や遊び感覚の中で少し難しい社会の仕組みを学べる環境って素晴らしいなと思います!

誰かに頼る前に、まずは自分で考えてみる・やってみる!
北出:タッチでいろんな『体験』をしていく中で、お子さんの成長って何かありましたか?
興味の幅が広がったのはもちろんですが、何よりも『まず自分で考えてやってみる!』という姿勢が出てきたんですよね!
北出:例えば、どんな場面で見られるようになったんですか?
最近、車で聞きたい曲リストを娘が自作していまして。ちょっとしたことなんですけど、今まで自分で調べてまとめるなんて、まったく無かったので正直びっくりしました(笑)
北出:最近やった『政治の授業』でも、その成長が見られました!自分が思う町の困りごととその解決策まで考えることができていたんですよね!
『まず自分で考えてやってみる!』という姿勢が急成長している印象です!

そうだったんですね!また娘にもその話を聞いてみます!
親が子どもに見せてあげられる世界には限りがあるからこそ...
北出:最後に、タッチに興味を持っている保護者さんに向けて、メッセージをお願いしてもよろしいでしょうか?
タッチは共働きやお子さんが多いご家庭にすごく合った習い事だと思います。親が子どもに見せてあげられる世界には限りがあるからこそ、1つの習いごとの中で、いろんな『体験』ができて、遊び感覚で社会の仕組みを学べるタッチはおすすめです! 『子どもにはいろんな経験をさせてあげたいけど、時間的に難しい...』と同じような悩みを持っている保護者さんはぜひ!
北出:本日はたくさんのお話を聞かせていただき、ありがとうございました!
『タッチ』が気になる方へ、無料体験授業にご招待!
『タッチって、もしかしたら自分の子どもにも合うかも...?』
と、少しでもご興味がありましたら、ぜひ無料体験会へご参加ください!
▼お申込みはこちら▼
※通常授業体験はおひとりさま一度まで無料となっています。
授業に関しまして、ご不安や、ご相談がある方はお気軽に以下までご連絡ください。
touch@coleyo.co.jp
075-285-1569
好奇心旺盛な子どもこそ"幅広い体験"を!《タッチ保護者インタビュー》
今夏で『タッチ』がついに1周年を迎えました!
記念としてタッチに通っている生徒の保護者さんにインタビューをさせていただきました。
『子どもにいろんな経験をさせてあげたい!けど、何をやらせてあげたらいいか分からない...』
そんなお悩みを持った中で、タッチと出会った今井さんへのインタビュー記事です!
タッチに通ってくれているこころちゃんにも、タッチのことを聞いてみました!

- 興味関心を広げてあげたい!でも、 "知る"だけでは満足しない…
- 『見る・聞く』から『やってみる』へ
- 子どもの興味関心を行動に変えるタッチの環境
- 『子どもにいろんな経験をさせてあげたい!』と思っている保護者さんへ
- 『タッチ』が気になる方へ、無料体験授業にご招待!
興味関心を広げてあげたい!でも、 "知る"だけでは満足しない…
タッチ北出:では、タッチに興味を持ったきっかけについてお伺いしてもよろしいでしょうか。
今井家では『楽しいと思うことを、ひたすら突き詰める人になれ!』という考え方を大切にしていて、そのためにまずは『娘の興味の幅を広げてあげたい』と思っていました。
北出:『まずは興味を持てることに出会う』というのは大切ですよね。
そうなんです。これまでも娘が『やりたい!』と興味を持てる習い事に通わせてきました。絵画教室だったり、オカリナ教室だったり。
ただ、いろんなモノに興味を持つものの、突き詰めて深めたい!と思えるモノには、今まで出会えてこなかったんです。それがちょっとした悩みでした。

北出:ちなみにお子さんは、今までってどんなものに興味を持っていたんですか?
目に入るものに興味を持って、例えば空とか、虹とか、ダンゴムシとか...さらに『なんで空は青いの?』と疑問を持ったりするんですよね。
本を読んで納得したり、『これはこうだよ』と教えたりするんですが、顔は不完全燃焼みたいなことがよくあって(笑)興味は持つけど、その先が広がらない、深まらない、そんな悩みがあったんです。その時、お友達のお母さんから、タッチの存在を紹介してもらったんです。
『見る・聞く』から『やってみる』へ
北出:『没頭できるほどの興味に出会えない...』その悩みを持つご家庭は多そうですよね。
そうですよね~。けど、タッチに通ってからは娘の興味に変化があったんです。
北出:そうなんですか!?どんな変化があったのか、お聞きしてもいいですか?
はい!授業で扱う金融や漁業、ウイルスのお話について、娘が『自分ごと』として向き合うようになったんです。ただ本で読むだけじゃなくって、身の回りにあるモノとして、捉えるようになったことが一番の成長です!
北出:ものすごい成長ですね!『自分ごとで向き合う』って、例えばどのような場面で見られるようになったんですか?
家でお魚を食べる時も、『お魚の特徴はね!』 って教えてくれるんです。授業で習ったことと、生活の中で出てくるモノを掛け合わせて、話すようになりました。

▼『漁業の授業』の詳細はコチラから!▼
子どもの興味関心を行動に変えるタッチの環境
➀自分でやってみて、発見するから、家族に伝えたくなる
北出:お子さんの興味に変化があった理由って、何だと思いますか?
そうですね。タッチの『自分でやってみるワーク』が娘には良かったんだと思います。ワークの中で、目の前で変化を見たり、何かを発見できる場面が多いことって、子どもの興味にすごい良い影響を与えると思います。
北出:ありがとうございます!その中で、お子さんが特に気に入っていた授業って何かありましたか?
『水の授業』ですね!授業が終わってから、『汚い水がきれいになったんだよ!コップを覗いたら向こう側が見えたんだよ!』って言ってきてくれて!自分でろ過装置を作って、目の前で変化を見れたことが本当に嬉しかったみたいです!
北出:そうだったんですね!授業をしている身としても、本当に嬉しいお話です!こころちゃんも授業受けてて、どんなところが楽しい?
自分で一度やってみるのが、すんごいおもろい!卵を落として割れない宇宙船作ったり、汚れた水をきれいにしたりとか!目の前で変わっていくのが見えるから、楽しいんだよね!

▼『水の授業』の詳細はコチラから▼
②子どもの可能性を発掘する、年24個のよのなか体験カリキュラム
北出:興味の幅も広がったとのことですが、タッチの授業で良かったところはありますか?
タッチでは年24個の授業があり、その中で『世の中ってこんなに楽しいよ!』ってことを、子どもの興味が湧くような視点で、投げかけてくださります。最初に話した『没頭できるほどの興味』を見つけるためには、いろんな興味に触れてみることが大切だと改めて思いました。
北出:授業でも、メモを取ったり、発言したりと、どんどん積極的になっている姿が見られます!
そうなんですね!私自身も、あんなに『やりたい!楽しい!』と娘が言うなんて思ってもなかったです。娘の可能性を勝手に決めちゃってたというか...。授業帰りに『今日はね~』と自慢げに話してくる娘を見て、嬉しく思っています!

『子どもにいろんな経験をさせてあげたい!』と思っている保護者さんへ
北出:最後にタッチに興味を持っている保護者さんに向けて、メッセージをお願いしてもよろしいでしょうか。
タッチでは、子どもたちが興味を持つことに対して、本気で取り組んでくださります。"やってみる"を通して楽しく学ぶことを具現化したような教室なので、『子どもにいろんな経験をさせてあげたいけど、何をさせたらいいか分からない...』と同じ悩みを持っている保護者さんにおすすめしたいと思います!
北出:本日はたくさんのお話を聞かせていただき、ありがとうございました!
『タッチ』が気になる方へ、無料体験授業にご招待!
『タッチって、自分の子どもにも合うかも...?』
と、少しでもご興味がありましたら、ぜひ無料体験会へご参加ください!
▼お申込みはこちら▼
※通常授業体験はおひとりさま一度まで無料となっています。
『興味はあるけど習い事が詰まっていて、今は通うのが難しい…』という方に向けて、
夏休みの短期集中プランもございますので、そちらも是非ご検討ください。
授業に関しまして、ご不安や、ご相談がある方はお気軽に以下までご連絡ください。
touch@coleyo.co.jp
075-285-1569
【タッチ】人工の右腕をつくる!?人体の仕組みを徹底解明!
7月後半に開催中のタッチコース『人体の授業』をご紹介します!
『人体の授業』☆無料体験会☆のご案内もあるので、ぜひ最後までご覧ください!
- 『人体の授業』の見どころ
- 腕が曲がる仕組みって、そうなってたのか!
- 【ワーク①】身近なアイテムだけで、筋肉をつくろう!
- 超高齢大国、日本を救う技術とは!?
- 【ワーク②】『老後の世界』を体験!
- 《7月末〆切》夏のタッチ短期集中プランについて
『人体の授業』の見どころ
授業では、人体の仕組みについて学び、『人工筋肉づくり』に挑戦します!
身近なアイテムだけを使って、筋肉と腕をつくることができるんです!

授業の中では老後の生活を体験するワークも!
高齢者の視力や筋力を体験し、そこで役立つ技術について学びます。

腕が曲がる仕組みって、そうなってたのか!
➀筋肉 ②関節 ③腱 ④骨
この4つが、腕を曲げる時に働いてくれています!

なんとなく腕を曲げる時、腕の中ではこんなことが起きています。
【腕が曲がる仕組み①】
まずは筋肉が縮みます。
ムキムキの人は、この筋肉を縮ませるパワーがすごいんです!

【腕が曲がる仕組み②】
続いて、筋肉が縮むことで腕の骨が引っ張られます。

【腕が曲がる仕組み③】
最後に、関節が曲がることで腕全体が曲がります。

4つ仕組みの連携プレーにより、私たちは腕を曲げることができています!
【ワーク①】身近なアイテムだけで、筋肉をつくろう!
『人工筋肉づくり』で役立つのが、さっき学んだ『腕が曲がる仕組み』です!
腕の仕組みを割りばしや風船、ストローなどを使い再現していきます。

▼▼▼完成した腕がこちら!▼▼▼

ポンプで空気を入れることにより、筋肉が縮み、腕が曲がる仕組みです!

『ムキムキの筋肉にするにはどうしたらいい?』
『より自然に曲がるようにするにはどうしたらいい??』
授業では、そんなことを考えながら、自分だけの右腕をつくっていきます。
超高齢大国、日本を救う技術とは!?
今や3人に1人が高齢者の日本。
2050年には若者1人で高齢者1人を支える社会が待ち受けています。

そんなの、絶対無理ですよね...?
そんな超高齢社会で活躍する!
そして、将来は皆さんも使うかもしれない🔧技術🔧を授業で紹介します。
いったい何の技術なのか...
ぜひ体験会で答え合わせしてみてください!
【ワーク②】『老後の世界』を体験!
タッチでは、超高齢化の話をして終わり...
とはいきません!
子どもたちがおじいちゃん、おばあちゃんになった時、どうなるのか。
腕の力が弱い、視力が弱い、耳が聞こえにくいなどなど...
今回は『老化アイテム』を使って、老化を体験します!

老後の世界がどんなものか、ぜひ授業で体験してみてください!
以上、『人体の授業』のチラ見せ予告でした!
《7月末〆切》夏のタッチ短期集中プランについて
『この夏、タッチの授業を受けてみたい!』
そんな方におすすめなのが、こちらのプランです。
夏休みの時間を使って、好きな授業を好きなだけ受講できるプランとなっています!
▼▼▼ご興味ある方はぜひ、以下の記事をご覧ください!▼▼▼
授業に関しまして、ご不安や、ご相談がある方はお気軽に以下までご連絡ください。
touch@coleyo.co.jp
075-285-1569
担当:橋本翼
【過去の授業もぜひご覧ください!】
《タッチ》夏の9種類から選べる短期集中プランを開講します!
今回はタッチコース短期集中プランのご案内です!
タッチコース短期集中プランについて
『タッチに興味ある!けど、普段は通う時間がない...夏休みだけなら行ってみたい!』
そんな方に向けたプランをご用意しました!

8月17日からの1週間で、9コの授業を日替わりで開催します。
興味がある授業だけを、時間がある夏休みにまとめて受けることができます!
各授業内容について
宇宙からの帰還 〜僕はキミを救いたい〜

8/17(水)9:30~11:30 or 14:30~16:30
紙とテープ、ハサミだけを使って制作した宇宙船に卵を乗せて、3メートルの高さから落とします!
「どんな形にすれば卵が割れないのか?」
「落とす向きはどっち方向にしたらいいのか?」
といった問いから図形の構造について学んだり、繰り返し考えてやってみる『仮説・検証』の大切さを学びます。
栄光のわり橋 建築士 〜強度が高い橋を建設せよ〜

8/17(水)12:00~14:00 or 14:30~16:30
割り箸とテープを使い、強度の高い橋の建設に挑戦します!
作った橋の上に2Lのペットボトルを置き、3秒間耐えることができたら成功です!
橋をかける溝は25㎝からスタートし、成功するたびに広げ、難易度を上げて行きます。
本物の橋の構造を学びながら、『仮説・検証』を繰り返し、より強度の高い橋の製作を目指します。
駄菓子屋を開業せよ 〜ものを買う・売る〜

8/18(木)9:30~14:00(2コマセット)
駄菓子屋を自分たちで開業し、『お商売』について学びます!
「どんな人に買ってもらいたいか?」
「そのために何を仕入れるか?」
と考えながら、限られた予算の中でやりくりし、 実際に駄菓子の販売まで行います。
授業の1回目駄菓子の仕入れを行い、授業の2回目で駄菓子の販売を開始します。
※この授業は2回連続で開催する授業となるため、2コマ分の料金が発生します。
透明な水のつくり方 〜キレイな水はどうやってできる?〜

8/19(金)9:30~11:30 or 14:30~16:30
普段飲んでいる『水』がどのように作られているかを学びながら、水をきれいにする『ろ過装置』づくりに挑戦します!
「材料を入れる順番をどうするか?」
「一気に注ぐ?それともゆっくり注ぐ?」
と考えながら、汚れた水を透明に変えます。
MAKE ENERGY 〜風の力で電気を作れ!〜

8/19(金)12:00~14:00 or 14:30~16:30
『電気』の重要性や使い道を学んだ上で、オリジナルの発電機づくりに挑戦します!
今回はペットボトルでプロペラを作ります。
「羽の枚数、何枚にしたら一番回るかな?」
「羽の先とんがらせてみよう!」
と考えながら、より大きな電気を生み出す発電機を目指します。
みんなの農園 〜農業は旬と投資が大事!?〜

8/22(月)9:30~11:30 or 14:30~16:30
タッチオリジナルのボードゲームを使い、野菜の仕入れから始まる農業ビジネスをゲーム形式で体験します。
野菜の仕入れから、作付け、収穫、販売を体験し、利益を上げることを目指します!
「どの時期に販売すれば、一番高く売れるかな?」
「そもそも、どの野菜が一番売れやすいんだろう?」
と考えながら、野菜の旬や農業での投資について学びます。
おさかな大解剖 〜魚の世界の食べる、食べられる〜

8/22(月)12:00~14:00 or 14:30~16:30
稚魚の観察やトビウオの解剖を通して、魚の仕組みとこれからの漁業で大切な『養殖』の必要性について学びます。
授業では稚魚の観察に挑戦し、みんな知っているイワシアユ、タコが登場します!
また、トビウオを解剖し、体の仕組みや人間にはないパーツを見つけ出します。
ミクロ探偵団 〜病気の正体判明のカギは顕微鏡?〜

8/23(火)9:30~11:30 or 14:30~16:30
医療の歴史を学びながら、顕微鏡を使って菌(コウジカビ)の観察をします!
わさびやニンニクなどといった調味料全8種類の中から、 最も抗菌効果のある組み合わせは何かを考え3つを選び出し、抗菌ソースを作ります!
「菌に強い調味料ってどれだろう?」
「どれくらいの分量や比率で混ぜるか?」
といったことを考えながら、納豆菌の抗菌を目指します。
人工の右腕 〜身近なアイテムで人工筋肉づくり〜

8/23(火)12:00~14:00 or 14:30~16:30
人体の仕組みや構造について学び、割り箸やストロー、風船で作れる人工筋肉づくりに挑戦します。
また、高齢者の視力や腕の力を体験できる「老化アイテム」を使い、老後の生活を体験するコーナーもご用意しています!
例えば、こんな授業の組み合わせはいかがでしょうか?
お子様の興味やご家庭での予定を踏まえて、授業のおすすめの組み合わせをご紹介します!
授業選びの際の、ご参考にご覧ください。
■『実験が大好き!』というお子様に向けて

これらの授業では実験を何度も繰り返す「仮説・検証」のプロセスを大切にしています。
1回1回の実験が面白いのはもちろん、何度も実験を繰り返すことで、成功に近づいていく楽しさも感じていただけます!
■『商売やお金に興味がある!』というお子様に向けて
 農業や小売をテーマに、お商売の仕組みやお金の動きを実践を通して、体験します。
農業や小売をテーマに、お商売の仕組みやお金の動きを実践を通して、体験します。
お金を使うのではなく、お金を生み出すためには、どのような視点や工夫が必要かについて学びます。
■『午前中しか空いてないけど、いっぱい受けたい!』というお子様に向けて

午前中で完結する授業を4つ体験するプランです。
1つ1つの授業テーマも異なるので、「いろいろな授業を受けてみたい!」というお子様にもオススメです!
お申込みについて
▼以下のURLから、お申込みください!▼
授業に関しまして、ご不安や、ご相談がある方はお気軽に以下までご連絡ください。
touch@coleyo.co.jp
075-285-1569
【タッチ】菌を見つけて、菌とたたかう!調味料で作れる抗菌ソースの開発に挑戦!
7月前半に開催中のタッチコース『菌の授業』をご紹介します!
『菌の授業』☆無料体験会☆のご案内もあるので、ぜひ最後までご覧ください!
- 『菌の授業』の見どころ
- 顕微鏡で見れる『ミクロの世界』って?
- 【ワーク①】酵母菌を見つけ出せ!ミクロ探偵団!
- 『菌の授業』が気になる方へ、無料体験会にご招待!
- 【裏話】散らかし癖で、抗生物質を開発!?
- 【ワーク②】菌に勝てる抗菌ソースを開発!
- 『菌の授業』が気になる方へ、無料体験授業にご招待!
『菌の授業』の見どころ
虫の羽にプランクトン、カビの正体まで...
今回は顕微鏡を使って、子どもたちと一緒に『ミクロの世界』に迫ります!

さらに、授業の最後には、細菌やウイルスとたたかう方法を伝授!
菌を倒す秘密兵器『抗菌ソース』をみんなで作ります!

顕微鏡で見れる『ミクロの世界』って?
何百倍に拡大してやっと見える...それが『ミクロの世界』です。

髪の毛と比べても、こんなに小さいミクロの世界。
顕微鏡を使えば、花粉や胞子、ウイルスの表面の様子まで観察することができます!
今回は、このなかでも『菌』の観察に挑戦します!
【ワーク①】酵母菌を見つけ出せ!ミクロ探偵団!
塩、片栗粉、醤油、砂糖、そして酵母菌。
ミクロ探偵団に任命された子どもたち!
5つの容疑者の特徴を観察し、酵母菌を見つけ出します!

★犯人の特徴★
➀白っぽい見た目をしている
②カクカクはしていない
③糸のようなものが見える
これが酵母菌を見つけ出すヒント!
果たして、顕微鏡を使いこなして、酵母菌を見つけ出すことはできるのか!?

ぜひ、☆無料体験会☆にて、チャレンジしてみてください!
『菌の授業』が気になる方へ、無料体験会にご招待!
少しでもご興味がございましたら、ぜひ一度、無料体験会へお越しください!

■開催日時
7/7(木)17:00〜19:00《菌の授業》
7/8(金)17:00〜19:00《菌の授業》
7/9(土)12:30〜19:00《菌の授業》
7/11(月)17:00〜19:00《菌の授業》
7/13(水)17:00〜19:00《菌の授業》
■場所
studioあお(北野天満宮から徒歩3分です!)
▼お申込みはこちら▼
※通常授業体験はおひとりさま一度まで無料となっています。
記事の続きもぜひご覧ください!
【裏話】散らかし癖で、抗生物質を開発!?
現代では当たり前となった抗生物質、開発されたのは20世紀になります。
イギリスの細菌学者、フレミングが作り出しました!

散らかせ癖が激しい彼は、実験中の器具を放置して旅行に...
帰宅後、実験していたシャーレを捨てようとすると、そこには菌を死滅させていた謎のカビが!
菌を死滅させたその物質は、ペニシリン(抗生物質)と名付けられました。
現代では当たり前となった抗生物質には、こんな裏話があったんですね...!
【ワーク②】菌に勝てる抗菌ソースを開発!
顕微鏡で菌の発見、観察に成功!
その後、授業では見つけた菌たちと戦う方法も学びます。

使える原材料は8種類!
原材料を混ぜ合わせ、納豆菌を撃退する抗菌ソースを作ります!

『それぞれの原材料にどんな特徴があるのか...』
『どの組み合わせにするのか...』
『何種類組み合わせるか...』
こんなことを考えながら、開発に挑戦します!
抗菌効果が高い場合、実験後に透明な部分の面積が広くなります!

フレミングさんのように、『まさかそれが!?』という意外な結果が出るかもしれません!
ここまでが『菌の授業』のご紹介でした!
『菌の授業』が気になる方へ、無料体験授業にご招待!
少しでもご興味がございましたら、ぜひ一度、無料体験会へお越しください!

■開催日時
7/7(木)17:00〜19:00《菌の授業》
7/8(金)17:00〜19:00《菌の授業》
7/9(土)12:30〜19:00《菌の授業》
7/11(月)17:00〜19:00《菌の授業》
7/13(水)17:00〜19:00《菌の授業》
■場所
studioあお(北野天満宮から徒歩3分です!)
▼お申込みはこちら▼
※通常授業体験はおひとりさま一度まで無料となっています。
授業に関しまして、ご不安や、ご相談がある方はお気軽に以下までご連絡ください。
touch@coleyo.co.jp
075-285-1569
担当:橋本翼
【過去の授業もぜひご覧ください!】
トビウオの解剖・稚魚の観察に挑戦!そして、今後の漁業のヒミツとは!?《漁業の授業レポート》
6月後半のタッチ授業レポート、今回は
『漁業の授業』をお届けします!
今回の授業では、子どもたちがトビウオの解剖に挑戦し、魚の特徴を解明しました。

『魚の特徴を知ること』が今後の漁業で、超重要に!
その理由も、この記事でお伝えして
いきます!
さらに子どもたちがドハマりのワーク『ちびっこ魚コレクション』についても、記事の最後でご紹介します!
トビウオの解剖に挑戦!
解剖では『脳』『目』『ヒレ』『エラ』『背骨』『耳石』の6つのパーツを取り出しました!
ピンセットとハサミを器用に使いながら、解剖を進めていきます。
『エラって、こんな形してるんや!』
『魚の脳って、ちっさ!』
『背骨が折れてしまった...』
と、こんな反応がありました!

取り出すことが難しい『耳石』を見つけた時は
『おおお!これが耳石かぁ!!』
と、大きな声が上がりました!

耳石ってなに?どんな仕組み?
続いて、解剖したパーツの仕組みについて学びました。
子どもたちが興味を持ったのは、読み方も分からない『耳石』でした!
耳石と書いて、『じせき』と読み、大きさは米粒ほどです。

魚は耳石により、バランスを保っており、人でいうところの『三半規管』の役割を持っています。
そして、ここまで読んでいただいた皆さんに1つご案内があります!
『漁業の授業』が気になる方へ、無料体験授業にご招待!
少しでもご興味がございましたら、ぜひ一度、無料体験会へお越しください!

■開催日時
・6月24日(金)17:00~19:00《漁業の授業》
・6月27日(月)17:00~19:00《漁業の授業》
■場所
studioあお(北野天満宮から徒歩3分です!)
▼お申込みはこちら▼
※通常授業体験はおひとりさま一度まで無料となっています。
記事の続きもぜひご覧ください!
注目されている『養殖』で、魚の仕組みを知ることが重要に!
『耳石』なんて、聞いたこともない魚の仕組みを知ることが、なぜ重要なのでしょうか?
その理由が『養殖』にあります。
今では当たり前となった『養殖』ですが、そこには魚の研究が欠かせません。

クロマグロの養殖で有名な近畿大学の養殖研究では、32年間の観察・研究により人工ふ化した稚魚が突然死する問題を解決しました。
養殖のためには『魚を知ること』が重要であり、今回はその一歩目としてトビウオの解剖に挑戦しました!
子どもたちがドハマりした『ちびっこ魚コレクション』
魚の特徴や仕組みを知るため、トビウオの解剖に加えて、『稚魚の観察』にも挑戦しました!

イワシやアユ、タコ、イカ、タチウオまで、今回観察した稚魚は20種類にもなりました!
たくさんいる稚魚の名前を、その特徴から探し出し、自分だけの稚魚図鑑を完成させました!

『これって、イワシかな?アユかな?』
『タチウオって、こんなに体長いんや!』
『タコの赤ちゃん、ちゃんと足が8本ある!』
と、稚魚の特徴をバッチリ観察できていました!
授業ではタコの赤ちゃんがなかなか見つからず、激レアだと知った子どもたちは
『タコの赤ちゃん、俺も私もほしい!』
と、タコ争奪戦となりました...(笑)
以上!授業レポートでした!
次回の授業は『菌』をテーマにした授業を行います。後日、予告記事も投稿するので、ぜひそちらもご覧ください!
『漁業の授業』が気になる方へ、無料体験授業にご招待!
少しでもご興味がございましたら、ぜひ無料体験会へお越しください!

■開催日時
・6月24日(金)17:00~19:00《漁業の授業》
・6月27日(月)17:00~19:00《漁業の授業》
■場所
studioあお(北野天満宮から徒歩3分です!)
▼お申込みはこちら▼
※通常授業体験はおひとりさま一度まで無料となっています。
授業に関しまして、ご不安や、ご相談がある方はお気軽に以下までご連絡ください。
touch@coleyo.co.jp
075-285-1569
担当:橋本翼
お魚の解剖から、漁業のヒミツに迫る!?《漁業の授業~予告編~》
6月後半に始まるタッチコース『漁業の授業』をチラっとお見せします!
『漁業の授業』の見どころ
今回の授業の見どころは『魚の解剖』です!
子どもたち自身がトビウオを解剖し、その体の仕組みを解明!そして漁業のヒミツに迫ります!

実は、こうして魚の仕組みや特徴を知ることが、今後の漁業で超重要となってくるんです。
『魚の解剖って...気になる!』
『魚の解剖が今後の漁業に欠かせないって、どういうこと?』
少しでも気になる方は、ぜひ続きもご覧ください!
ここから少しだけ授業をお見せします!

ワーク:トビウオを自分の手で解剖!
今回、体の仕組みを解明するのはトビウオです!
まずは、トビウオの7つのパーツを取り出すことに挑戦します!

その後、解剖したトビウオを題材に『意外と知らない魚の特徴』について説明します!
例えば、みんな知っている『エラ』ですが、実はプランクトンを捕まえる仕組みがあるんです。『さいは』という部位で海水をろ過して、その中にいる小さなプランクトンを捕まえます。

解剖の中で、こうした豆知識もお伝えしていきます!
そして、この解剖で得た魚の知識が今後の漁業で重要になってきます。
魚の仕組みを知ることがなぜ大切?
その理由は魚の養殖にあります。
漁業では近年『獲りすぎ』が問題となり、漁獲量が減少しています。そこで注目されるようになったのが養殖です!

そして2030年には世界の養殖の割合が天然の漁獲量を上回るとされています。

(引用:第1章 特集 養殖業の持続的発展|平成25年度 水産白書)
そんな養殖ですが、より美味しく、繁殖しやすい養殖魚を開発するために、日々研究がおこなわれています。
日本では近大マグロが有名ですね!
養殖のためには『魚を知ること』が重要であり、解剖により魚の仕組みを解明することは、養殖研究の第一歩となるわけです!

実は、まだまだ見どころがある...!?
授業当日は魚の解剖の他にも、漁業のヒミツに迫るワークが盛りだくさんになっています!
『食物連鎖』『観察』『タコの赤ちゃん』
この3つが残りのワークのキーワードになります。
気になった方は、ぜひ授業当日に答え合わせをしてみてください!
ちなみにですが...
実は私たちも海に出て、漁業体験してきました!

授業の中で、漁業体験のお話もできればなと思います!
ここまでが『漁業の授業』チラ見せ予告でした!!
■『漁業の授業』の体験をご希望の方へ
 通常授業の体験参加が可能です。6月後半は『漁業』をテーマとした授業で、子どもたちと漁業のヒミツに迫ります!。以下よりお申し込みください。
通常授業の体験参加が可能です。6月後半は『漁業』をテーマとした授業で、子どもたちと漁業のヒミツに迫ります!。以下よりお申し込みください。
※通常授業体験はおひとりさま一度まで無料となっています。二度目以降のご参加は通常料金をいただきますので、お気をつけください。
■オンライン授業への参加をご希望の方へ
『ちょっと気になるけど、授業に参加するか迷う...』
そんな方に向けて、より気軽に参加できるオンライン授業もご用意しております!
こちらも無料で体験ご参加が可能です。是非一度お試しください。

授業に関しまして、ご不安や、ご相談がある方はお気軽に以下までご連絡ください。
touch@coleyo.co.jp
075-285-1569
担当:橋本翼